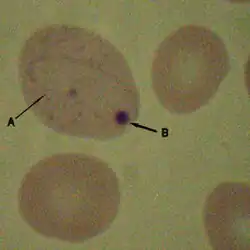

Howell-Jolly-Körperchen
B: Howell-Jolly-Körperchen
Howell-Jolly-Körperchen (engl. Howell-Jolly bodies) sind pathologische Zellkernfragmente in den normalerweise kernlosen Erythrozyten, die bei Asplenie oder bei hämolytischen und megaloblastären Anämien vorkommen können. Diese Kernreste bestehen aus DNA-Resten und werden normalerweise beim Durchtritt durch die Endothelspalten in der Milz aus den Erythrozyten entfernt. Nach einer Splenektomie bzw. bei Asplenie sollten Howell-Jolly-Körperchen im Blutausstrich zu finden sein. Ist dies nicht der Fall, so deutet dies auf das Vorhandensein einer Nebenmilz hin.[1]
Einzelnachweise
- ↑ Kapitel Milz In: Basislehrbuch Innere Medizin 4. Auflage, 2008, S. 305.
Literatur
- H. Renz-Polster, S. Krautzig (Hrsg.): Basislehrbuch Innere Medizin 4. Auflage. Elsevier, München 2008, ISBN 978-3-437-41053-6.